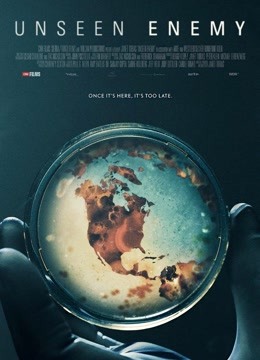
看不见的敌人

《看不见的敌人》电影
接下来由 追剧吧 为您介绍看不见的敌人电影相关信息如下
是对 21 世纪人们正在经历一系列疾病的基本探索,这些疾病曾经只是爆发,但现在已经成为全面的流行病。通过对三种流行病:埃博拉、流感和寨卡病毒的案例研究,向公众解释了我们面临的这种增加的风险,以及社会和个人可以共同努力减少这种风险的方式。在全球范围内,我们遇到了医生、疾病侦探和日常生活中的人们,他们经历了一场流行病的恐怖,并发生了深刻的变化。流行病带来了人类最好和最坏的行为,其影响远远超过疾病和死亡的代价。
看不见的敌人追剧吧在线观看,提供看不见的敌人电影在线播放和下载服务,资源丰富,虽然有少量广告但影响不大,播放渠道整合了看不见的敌人电影全集,看不见的敌人电影下载功能也比较实用。
对电影看不见的敌人质量有要求的观众可以关注这个网站,它提供看不见的敌人电影完整版高质量的在线播放,支持电影看不见的敌人完整版4K播放,播放速度流畅,即使是快进快退也不会卡顿。除了看不见的敌人电影完整版免费观看高清,网站还有和看不见的敌人完整版类似影片,方便观众挑选和看不见的敌人电影全集完整版免费观看高清一样高质量影片。
以上就是关于看不见的敌人电影的信息。如果你还想查看关于电影看不见的敌人相关影片请前往 电影 分类页